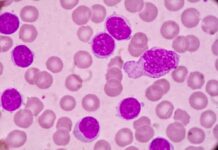
Zanubrutinib Shows Sustained Progression-Free Survival at Five Years

Recent research reveals that socioeconomic status (SES), particularly lower educational attainment, can be a barrier to allogeneic hematopoietic cell transplantation(allo-HCT) among patients with acute myeloid leukemia (AML). The findings were presented at the ASH Annual Meeting.
“We have previously shown that age, comorbidity burden, cytogenetic risk, and geriatric health significantly impact the likelihood of receiving allo-HCT and mortality among AML patients,” wrote the authors, led by Natalie Wuliji, DO, of Fred Hutchinson Cancer Center in Seattle, Washington.
The researchers sought to further understand the effects of SES on this patient population. They conducted a prospective, observational study at 13 sites that enrolled 695 patients with AML. They assessed several SES factors according to patient zip code, including:
- Median household income;
- Percentage of adults in the area who were 25 years or older and had less than a high school education;
- Percentage of households in the area below the poverty level;
- Percentage of households receiving food assistance;
- Percentage of housing units with a high proportion of income spent on housing;
- Percentage of housing units with a second mortgage, home equity loan, or both; and
- Percentage of households receiving supplemental income (e.g., social security, disability).
Multivariable analysis showed that when the percentage of people in the area with less than a high school education increased by 10%, the likelihood of HCT decreased by 32%. With a 10% increase in the number of people receiving food assistance, there was a 14% decrease in the likelihood of HCT. And with a 10% increase in households receiving supplemental income, there was a 34% decrease in the likelihood of HCT.
The study found little evidence of associations between median area income or poverty level and overall mortality after HCT. However, the study did find a slightly increased chance of mortality after HCT with higher percentages of residents with less than a high school education.
“This highlights the need for targeted interventions to improve access to HCT for patients from lower socioeconomic backgrounds. Efforts should focus on addressing financial barriers, improving health literacy, and enhancing support systems to ensure equitable access to life-saving treatments,” the authors concluded.
https://ash.confex.com/ash/2024/webprogram/Paper202664.html
Reference
Wuliji N, Gooley T, Jones S, et al. Impact of socioeconomic factors on access to and outcomes of allogeneic hematopoietic cell transplantation (allo-HCT) for acute myeloid leukemia (AML): a multi-center observational study. Abstract #6. Presented at the 66th American Society of Hematology Annual Meeting and Exposition; December 7–10, 2024; San Diego, California.